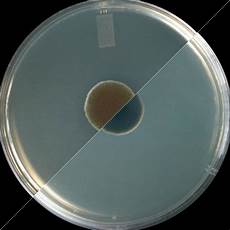
Cladosporium Mold

Turkish Cladosporium Mold Suppliers and Cladosporium Mold Turkey Manufacturer Companies Listing Directory from Forie.Network
Let us help you to deliver your inquiry about the topic of Cladosporium Mold to the supplier(s) quickly.
This post you published is a manufacturer, seller or buyer. Will be shared with thousands of companies.
You can reach thousands of companies, see the offers that come to your request and enhance your trade.